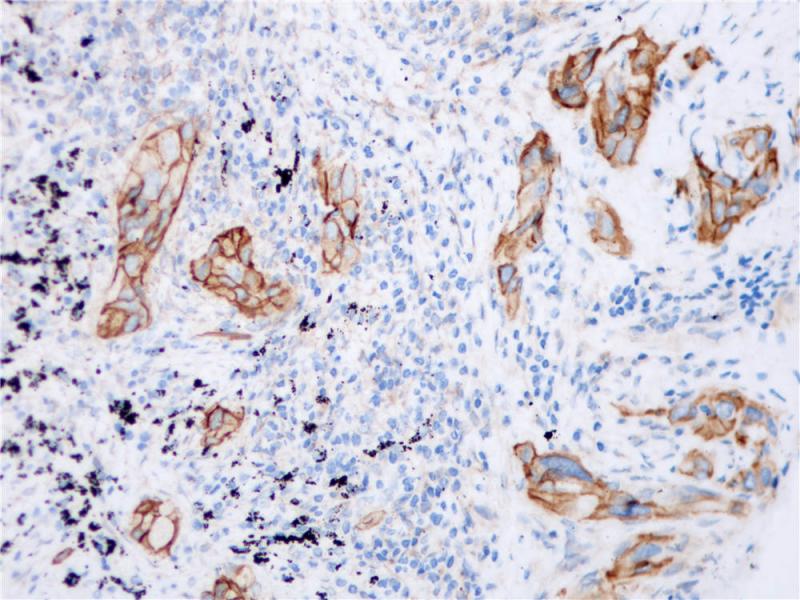
肺癌 EGFR (BP6097) 染色

产品中心

肝 EGFR (BP6097) 染色
肺癌 EGFR (BP6097) 染色
EGFR 重组兔单克隆抗体
EGFR是一种170kDa的跨膜蛋白,由胞外功能区(结合配体)、跨膜区和具有酪氨酸激酶活性的胞内区组成。EGFR表达于多种正常组织,特别是复层上皮和鳞状上皮的基底层。在许多上皮源性肿瘤中均有过表达现象,如乳腺癌、膀胱癌、胰腺癌、胃癌及甲状腺癌等,其阳性表达表明预后差。
Specifications
- 目录号
- BX50092
- 克隆号
- BP6097
- 阳性对照
- 肺癌
- 亚细胞定位
- 细胞膜/细胞质
- 组织类型
- FFPE
- 修复方式
- HIER
- 稀释比
- 1:100-1:200
- 规格
- 100μl/vial, 1ml/vial
- 用途
- RUO
Reference
1.Brustmann H, et al. Int J Gynecol Pathol. 2011 Jan; 30(1):76-83.
2.Vranic S, et al. Hum Pathol. 2010 Nov; 41(11):1617-23.


